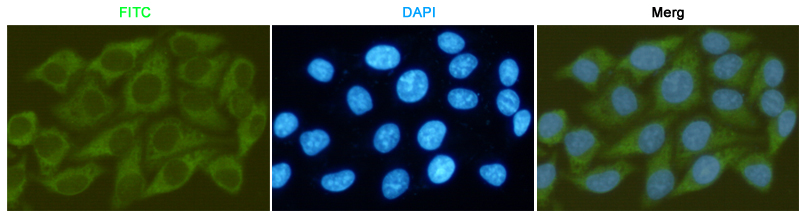

-
Product Name
Anti-GSK3 beta (2E6) Mouse antibody
- Documents
-
Description
GSK3 beta (2E6) Mouse monoclonal antibody
-
Tested applications
WB, ICC/IF, IP, FC
-
Species reactivity
Human, Mouse, Rat
-
Alternative names
Glycogen Synthase Kinase 3 Beta; Glycogen synthase kinase-3 beta; GSK 3 beta; GSK-3 beta; GSK3B; GSK3B_HUMAN; GSK3beta isoform; Serine/threonine-protein kinase GSK3B. antibody
-
Isotype
Mouse IgG2a
-
Preparation
Antigen: Purified recombinant GSK-3β protein fragments expressed in E.coli.
-
Clonality
Monoclonal
-
Formulation
PBS(pH 7.4) containing with 0.03% Proclin300 and 50% glycerol.
-
Storage instructions
Store at 4°C short term. Store at -20°C long term. Avoid freeze / thaw cycle.
-
Applications
WB: 1/1000
;ICC: 1/200
-
Validations

Western blot analysis of extracts from A549, Hela, 3T3 and Rat Brain cell lysates using GSK-3 beta mouse mAb(1:1000 diluted).Predicted band size:46KDa.Observed band size:46KDa.
Immunocytochemistry staining of HeLa cells fixed with -20℃ Methanol and using GSK-3 beta mouse mAb (dilution 1:200).

Immunoprecipitation analysis of Hela cell lysates using GSK3 beta (2E6) Mouse mAb.GSK-3 beta Rabbit mAb was used for the western blot analysis (1:1000 diluted).
-
Background
Swiss-Prot Acc.P49841.Constitutively active protein kinase that acts as a negative regulator in the hormonal control of glucose homeostasis, Wnt signaling and regulation of transcription factors and microtubules, by phosphorylating and inactivating glycogen synthase (GYS1 or GYS2), EIF2B, CTNNB1/beta-catenin, APC, AXIN1, DPYSL2/CRMP2, JUN, NFATC1/NFATC, MAPT/TAU and MACF1. Requires primed phosphorylation of the majority of its substrates. In skeletal muscle, contributes to insulin regulation of glycogen synthesis by phosphorylating and inhibiting GYS1 activity and hence glycogen synthesis. May also mediate the development of insulin resistance by regulating activation of transcription factors. Regulates protein synthesis by controlling the activity of initiation factor 2B (EIF2BE/EIF2B5) in the same manner as glycogen synthase. In Wnt signaling, GSK3B forms a multimeric complex with APC, AXIN1 and CTNNB1/beta-catenin and phosphorylates the N-terminus of CTNNB1 leading to its degradation mediated by ubiquitin/proteasomes. Phosphorylates JUN at sites proximal to its DNA-binding domain, thereby reducing its affinity for DNA. Phosphorylates NFATC1/NFATC on conserved serine residues promoting NFATC1/NFATC nuclear export, shutting off NFATC1/NFATC gene regulation, and thereby opposing the action of calcineurin. Phosphorylates MAPT/TAU on 'Thr-548', decreasing significantly MAPT/TAU ability to bind and stabilize microtubules. MAPT/TAU is the principal component of neurofibrillary tangles in Alzheimer disease. Plays an important role in ERBB2-dependent stabilization of microtubules at the cell cortex. Phosphorylates MACF1, inhibiting its binding to microtubules which is critical for its role in bulge stem cell migration and skin wound repair. Probably regulates NF-kappa-B (NFKB1) at the transcriptional level and is required for the NF-kappa-B-mediated anti-apoptotic response to TNF-alpha (TNF/TNFA). Negatively regulates replication in pancreatic beta-cells, resulting in apoptosis, loss of beta-cells and diabetes. Phosphorylates MUC1 in breast cancer cells, decreasing the interaction of MUC1 with CTNNB1/beta-catenin. Is necessary for the establishment of neuronal polarity and axon outgrowth. Phosphorylates MARK2, leading to inhibit its activity. Phosphorylates SIK1 at 'Thr-182', leading to sustain its activity.
-
References
- Cancer/testis antigen PIWIL2 suppresses circadian rhythms by regulating the stability and activity of BMAL1 and CLOCK
Related Products / Services
Please note: All products are "FOR RESEARCH USE ONLY AND ARE NOT INTENDED FOR DIAGNOSTIC OR THERAPEUTIC USE"
